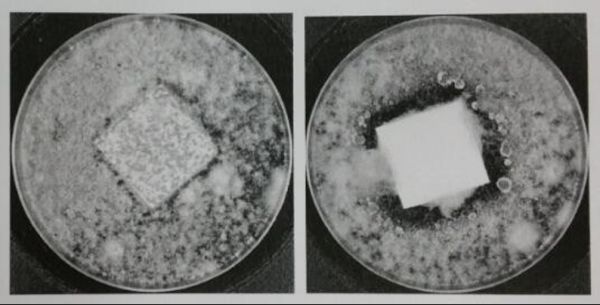

精装住宅品质健康提升进行时,立邦工程加速赋能美好生活
近年来,在国家政策的积极推动和购房市场的强烈需求下,精装修成品住宅成交比重逐年上升。2017年,住房和城乡建设部印发《建筑业发展"十三五"规划》,要求到2020年新开工全装修成品住宅面积达到30%。截止2019年9月全国各地共颁布了有关精装全装的政策83次,涉及27个省市。2017年,愿意购买精装房的消费者比例为26.8%,预计2020年可达39.5%。随着全国各地区精装修相关政策的不断出台,以及消费者购买精装房意愿的逐渐上升,我国精装修项目规模及渗透率得到迅速提升。
精装修比例的不断扩大,也为涂料行业带来了新的增长契机。内墙涂料集采化趋势加强,住宅领域涂料消费需求在工程端占比逐步提升。同时,进入后疫情时代,室内居住空间的健康、环保、安全也变成刚性衡量指标。国内百强房企开发商已将产品力增值的重心,着力于"健康型"成品住宅的建设。
立邦工程主要面向公建、房地产等建筑工程渠道客户。十多年来,立邦工程已为中国23亿平米建筑刷新空间,为千千万万的精装商住房涂刷室内墙面,见证千万户家庭的美好生活。每年在工程领域,会有数亿平米的建筑选择立邦工程涂料。立邦工程已与全国近200家地产开发商保持长效合作关系,并连续9年获得《500强地产开发企业首选涂料供应商》第一品牌。为客户提供从内、外墙到地面,从底到面的整体化涂装解决方案。伴随着"健康型"成品住宅的建设趋势,立邦亦着力创新和提升内墙的"健康科技",用心为住宅空间提升健康指数。
拒绝VOC 做环保的精装修成品房
入住新房,怎能被刺鼻异味打扰,打造健康居住环境,立邦以"净味"和"分解甲醛"为内墙产品的核心技术力量,为地产开发伙伴提升住宅产品的"健康力"。立邦工程内墙涂料产品体系全线采用立邦"净味技术",大幅降低涂料中的可挥发物质,超低VOC含量,远远低于国家标准规定的有害物质限量值,符合十环认证标准。

南京九都会采用立邦工程内墙产品体系
国内知名智能终端品牌在深圳的办公大楼在涂装了立邦工程内墙产品体系后,邀请国内领先的空气治理公司AY进行了专业空气净化,并特邀全球领先的检验、鉴定、测试、认证机构SGS对空气质量进行全面检测,结果全部达标。

国内知名智能终端品牌在深圳的办公大楼采用立邦工程内墙产品体系

室内空气质量检测显示甲醛、苯系物、VOC检出量均低于限量值
长效抗菌防霉 做健康的精装修成品房
确保室内空间卫生,减少健康危害,立邦工程抗菌内墙体系能在有效杀灭细菌的同时,摧毁细菌赖以存活和生长的生活环境,并有效抑制细菌的进一步繁殖,空间墙面的抗菌性能和抗细菌耐久性都≥99%,达到了抗菌I级标准,符合HG/T3950-2007《抗菌涂料》标准。


立邦医疗级抗菌内墙体系用于2022年冬奥会及冬残奥会定点医院
墙面发霉一直是住宅居家常见顽疾之一,长期接触和吸入霉菌, 可引发呼吸道疾病和过敏症状等。立邦工程抗霉内墙体系,具有优良的防霉性能,在保持良好通风,做好基层及墙面防水的基础上,可有效避免室内空间霉菌反复生长。按照GB/T 1741-2007检测,满足耐霉菌性0级要求,应用于易滋长霉菌的环境中,能较长时间防止涂膜表面长霉,持久地保持漆膜的装饰效果。
轻轻松松消毒 做安全的精装修成品房
疫情也带来一系列生活方式的改变,用酒精、84进行室内消毒逐渐成为居家的日常事项。而含氯消毒剂有一定的腐蚀性,酒精则有一定的刺激性,室内空间的高频消毒,对于墙面耐化学品性能和耐污性能带来更高要求。立邦工程对于易感人群聚集区域和一些有功能性需求的公建项目,所推荐应用的水性环氧抗污内墙体系以及水性聚氨酯抗菌体系,在具备防霉抗菌功能的同时,也能高效抵御多种污渍和消毒用品对墙面的污染,耐污易清洁,减少室内清洁工作量。

立邦工程以"环保、健康、安全"三大涂装要点守护精装修成品房的居住环境墙面安全,为住宅刷新健康标准。秉承着"刷新美好生活空间"的企业使命,立邦工程自2008年北京奥运会的场馆建设开始,参与北京大兴机场、上海浦东机场、2019世界园艺博览会、2022冬奥会及冬残奥会、2022杭州亚运会等国家级重大公共设施的建设。在为中国打造美好生活空间的路上,立邦工程专注于以卓越的产品,精工的品质,并始终持守着从"好"到"更好"的用心。
网址:精装住宅品质健康提升进行时,立邦工程加速赋能美好生活 https://www.jiaju82.com/news-view-id-728062.html

